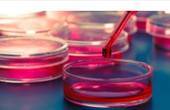
Сторожинецька лікарня переплатить новоствореному підприємцю понад 100 тисяч за аналізатор крові

Суспільство

Під час перерахунку голосів Чернівецька міська виборча комісія визнала недійсними більшість бюлетенів з дільниці, що розташована у Чорнівці. На них не було печаток. Голова дільничної комісії каже, що це трапилось через необізнаніс...
04.11.2020, 22:16
0

Ігор Баб'юк, політолог, заступник голови обласної організації Комітету виборців України:
«Дуже складна процедура підрахунку голосів на виборчій дільниці. Члени дільничних комісій могли неправильно порахувати голоси, невірно...
04.11.2020, 18:02
0

Перукарні не забороняють, а ресторани — цапи-відбувайли: у Чернівцях підприємці проти рейдів поліції
Тиждень тому у Чернівцях запровадили додаткові протиепідемічні заходи, крім тих, які традиційно діють у місті зі статусом «червона зона». З 27 жовтня усі заклади громадського харчування повинні зачинятись о 18 год. О...
04.11.2020, 17:45
0

Уряд виділив майже 9 мільйонів гривень на відновлення газопроводу, який влітку пошкодив паводок. Через нього забезпечують газом шість сіл Вижниччини – понад три тисячі домогосподарств.
Таке рішення прийняли на засі...
04.11.2020, 17:40
0

На Вижничинні незаконно знищили зелених насаджень на суму 256 тис.грн
Державною екологічною інспекцією Карпатського округу за розглядом звернення громадянина проведено позапланову перевірку щодо фактів незаконної вирубки дерев в л...
04.11.2020, 17:29
0

Ще два заклади охорони здоров'я отримали гуманітарне обладнання від ГО "Гільфе"
Під час своєї діяльності ГО «Гільфе» отримує неодноразові звернення від закладів охорони здоров'я області, щодо нестачі матрац...
04.11.2020, 17:18
0

В Чернівецькій області громадські організації допомагають лікувальним закладам боротись з короновірусом
Громадська організація "Гільфе" передала медичним закладам Чернівецької області більше ніж 9 тонн гуманітарної допомоги, до ск...
04.11.2020, 17:12
0

3 листопада У Чернівецькій області стартував проєкт пересувних відділень від Укрпошти. Перші 6 авто з точкою базування у Кельменцях обслуговуватимуть 36 населених пунктів Кельменецького та Сокирянського районів. До кінця листопада...
04.11.2020, 17:08
0

Про міфи та реальність строкової служби майбутнім строковикам
25-річний киянин Роман Загородній нещодавно звільнився в запас після проходження строкової військової служби в Чернівецькому дес...
04.11.2020, 13:57
0

Оцінки українців щодо останніх резонансних подій
Аудиторія: населення України віком від 18 років і старші в усіх областях, крім тимчасово окупованих територій Криму та Донбасу. Вибірка репрезентативна за віком, статтю і типо...
04.11.2020, 13:51
0
Сторожинецька центральна районна лікарня (Чернівецька область) 30 жовтня підписала договір із приватним підприємцем Владиславом Шнайдером на закупівлю аналізатора крові за 311 тис. грн. Про це стало відомо з порталу публічних заку...
04.11.2020, 13:22
0

Міська лікарня №1 Чернівецької міськради за результатом відкритих торгів уклала договір із ТОВ «Формедікал» на закупівлю рентген апарату за 4,41 млн грн. Про це повідомляється на сайті електронних закупівель Prozo...
04.11.2020, 13:19
0

Чернівецька міська територіальна виборча комісія має перерахувати голоси з 21 виборчої дільниці. Сьогодні комісія продовжить рахувати голоси з шостої дільниці.
Чернівецька міська ТВК продовжує перерахунок голосів. Попередньо плану...
04.11.2020, 13:13
0

3 листопада 1918 року у Чернівцях відбулися велелюдні народні збори. Віче проголосило возз'єднання Північної Буковини із Західноукраїнською Народною Республікою та подальшу злуку з «Великою Україною».
Істо...
03.11.2020, 23:47
0

Суд в Мілані розглянув апеляцію у справі Віталія Марківа та вирішив його виправдати.
Він повертається до України, повідомила омбудсменка Людмила Денісова.
"Віталій виступив у суді. Виступив стримано, гідно і емоційно. Він сказа...
03.11.2020, 21:55
0

Приміщення обласного шкірно-венерологічного диспансеру, що на вулиці М. Лермонтова, 6 у Чернівцях законсервували ще у 2011 році, після оптимізації закладу. Із того часу будівля площею майже у 640 квадратних метрів порожня та відк...
03.11.2020, 18:42
0

Буковинські аудитори виявили втрат на суму понад 1,5 млн грн під час ревізії державного професійно-технічного навчального закладу «Чернівецький професійний будівельний ліцей».
Фахівці Управління Західного офісу Д...
03.11.2020, 18:28
0

Буковинці отримали звання із нагоди річниці Буковинського віча
Із нагоди річниці Буковинського віча голова Чернівецької обласної державної адміністрації Сергій Осачук вручив буковинцям присвоєні Президентом почесні звання. Про це...
03.11.2020, 17:41
0

В автівці, що знесла ворота Чернівецького національного університету та врізалась в центральний корпус, знайшли пакетик з канабісом. Результатів освідування водія ще немає.
Про це повідомила прессекретарка нацполіції в Чернівецькі...
03.11.2020, 16:46
0





